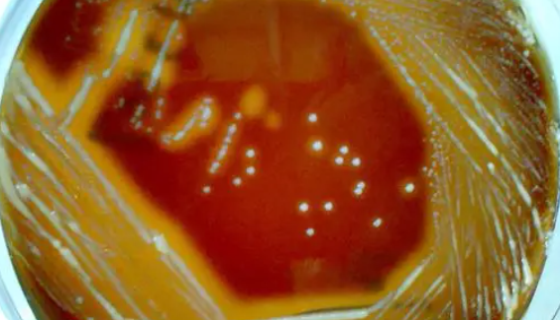
ATCC 49753 贪婪丙酸杆菌知识概述及培养与保藏！

ATCC MYA-2338 辣椒疫霉菌 百欧博伟生物
辣椒疫霉是一种霉菌,在CA上菌落呈放射状、絮状,气生菌丝中等...

人神经元细胞的主要用途与使用方法及注意事项!
人神经元细胞(HN)提取于人脑组织,原代培养冻存。仅供科研研...

食淀粉乳杆菌的培养条件与注意事项及打管说明!
食淀粉乳杆菌是Lactobacillus属的微生物,原产地为...

人正常结直肠粘膜细胞收到后处理方法与培养步骤!
人正常结直肠粘膜细胞收到后的处理方法与培养步骤及注意事项有哪...

乳酸杆菌属——用于发酵制乳制品和生产青贮饲料
乳酸杆菌属是Lactobacillus属的微生物,原产地为中...

解藻弧菌(溶藻弧菌)的培养方法与注意事项!
解藻弧菌(溶藻弧菌)的培养与打管说明及注意事项有哪些?
ATCC 49753 贪婪丙酸杆菌知识概述及培养与保藏!
贪婪丙酸杆菌是Propionibacterium属的微生物,...

HLF-A人肺上皮细胞的复苏与传代及冻存操作说明!
人肺上皮细胞HLF-a取自女性供体,不规则形态。仅用于科学研...

橘青霉的形态特征与生长习性及鉴定与培养方法!
橘青霉,本种的分生抱子面通常呈现典型的蓝绿色,产生大量的黄色...